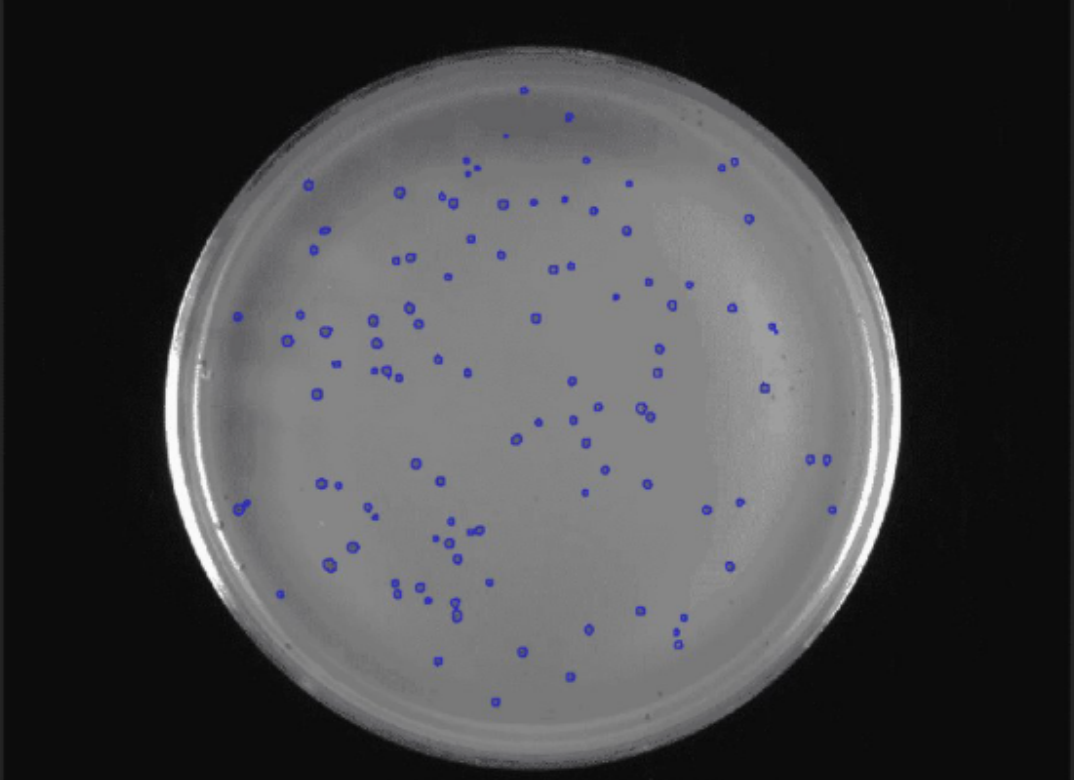

在现代工业生产中,企业面临着多样化、复杂化的检测与分析需求。产品种类繁多、精度要求高、实时性强的场景,为传统检测手段带来了巨大挑战。而DaoAI World作为一款以AI驱动的工业智能平台,通过其独特的算法优势和灵活的适配能力,帮助企业高效解决难题。核心能力有:
少样本学习:仅需少量样本即可快速完成模型的构建和训练,帮助企业在短时间内实现应用落地。
高度适配性:从宏观的产品检测到微观的图像分析,覆盖多种行业场景,为不同需求提供定制化支持。
极速运算:检测速度达毫秒级,满足工业生产中对实时性和效率的高标准要求。
精准可靠:具备像素级精度,确保产品检测和分析结果达到工业级别的严苛质量标准。
泛工业应用
1. 产品一致性检测

问题:客户拥有成千上万种产品类别,产品之间外观极为相似,需要一个具体的指标来判断两个批次产品是否满足一致性要求。
解决方案:DaoAI World的产品一致性评估AI模型,能够计算两个不同产品的相似度。客户可根据相似度判断产品的一致性,从而实现快速、准确的质量评估,保障生产标准统一。
2. 产品检索

问题:面对成千上万种产品类别,客户需要通过拍照快速识别产品种类,提高管理效率。
解决方案:通过DaoAI World产品检索AI模型,系统可利用客户数据库中的产品外观数据,与拍摄照片进行对比,快速检索并准确识别产品类别。该功能大幅缩短了产品分类和管理的时间,提升了操作效率。
3. 产品对比

问题:香烟制造商需要确保生产出的香烟型号与系统中记录的一致,但条形码扫描可能存在失败的情况,因此需要通过视觉手段进行辅助判断。
解决方案:DaoAI World的产品一致性评估AI模型,通过对比系统中记录的香烟外观数据与实物拍摄图像,判断是否为同一型号香烟。该方案为客户提供了更可靠的产品验证手段,降低生产错误率。
4. 电镜图像分析


问题:客户需要利用电子显微镜扫描晶体材质,并统计晶体的平均大小和直径。然而,晶体种类多样且复杂,传统手动分析效率低下。
解决方案:DaoAI World分割模型,能够自动识别和区分显微镜图像中的晶体,精准统计其大小和直径,极大提高了晶体分析的效率和准确性,为材料研究和优化提供了可靠数据支持。
5. 实验室研究:气泡观察
问题:实验室研究中,客户通过高分辨率设备观察气泡,需要统计气泡的数量、大小及其随时间的变化规律。
解决方案:DaoAI World计数模型,可实时记录气泡的数量和尺寸,并跟踪长时间的变化情况,为客户提供详细的实验数据支持。这种自动化分析方式,显著减少了人工统计的工作量。
智能赋能工业未来
DaoAI World凭借其强大的AI能力和灵活的适配性,已在多个行业和场景中实现了落地应用。从宏观的一致性检测到微观的实验室研究,DaoAI World不仅帮助企业显著提升生产效率,还降低了成本和人力投入。
在工业智能化转型的浪潮中,DaoAI World正以其创新的技术和精准的解决方案,为企业创造更多价值。如果您的企业正在面临检测或分析难题,欢迎与我们联系,让DaoAI World助力您的工业智能化升级!
微链道爱专注于 AI 视觉是下一代人工智能机器人研究企业。在视觉大模型、虚拟世界构建、高速 3D 成像、机器人智能运动控制等领域,已经积累丰富的学术和行业经验。DaoAI World 是一个集数据标注、模型训练为一体的AI视觉应用研发团队协作平台,最快半小时内可以训练一个AI视觉应用智能体。详情请见https://www.welinkirt.com/
























 被折叠的 条评论
为什么被折叠?
被折叠的 条评论
为什么被折叠?








